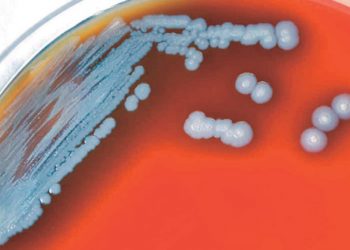
Detectan bacteria mortal en agua y suelo de EU

Confirman orden de usar cubrebocas en escuelas
AGENCIAS AUSTIN, Texas-- La orden ejecutiva del gobernador republicano de Texas Greg Abbott que prohíbe a los distritos escolares imponer mandatos de uso de mascarillas en las escuelas para evitar la propagación de la COVID-19 ha sido confirmada por un panel dividido de la corte federal de apelaciones. El fallo...
Leer MasDetails